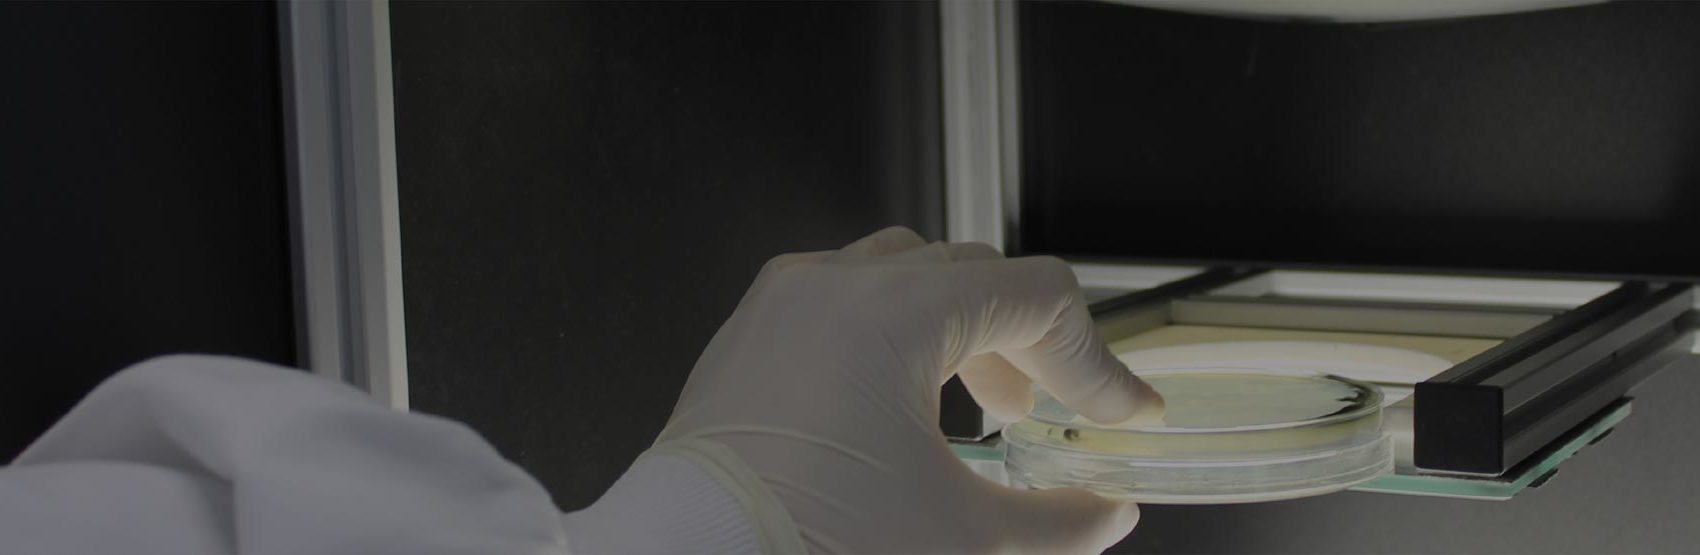

Suscríbete a nuestra newsletter

En lo que va de año, se ha notificado una veintena de alertas alimentarias en nuestro país. La integración de tecnologías fotónicas y de aprendizaje automático pretende ser una herramienta de ayuda para los laboratorios de análisis microbiológico con el fin de garantizar la seguridad alimentaria. Con la introducción de estas nuevas tecnologías es posible ofrecer resultados cada vez más rápidos y exactos. En AINIA hemos desarrollado un prototipo que ofrece la posibilidad de visualizar las placas de cultivos en una pantalla junto con información gráfica añadida por el usuario.
Este 2019 será recordado, entre otras cosas, por el brote de listeriosis más grave ocurrido en nuestro país (del que se tiene conocimiento) y del cual hemos hablado desde la perspectiva de cómo prevenir y controlar la Listeria en la industria alimentaria.
Las toxiinfecciones alimentarias son enfermedades que se producen por la ingesta de alimentos contaminados por microorganismos patógenos o sus toxinas. Entre las más comunes cabe destacar las provocadas por Salmonella, Listeria monocytogenes (liseriosis), Escherichia coli y Campylobacter. Según el Informe Anual de Fuentes y Tendencias de Zoonosis y Agentes Zoonóticos de 2017 publicado por la Agencia Europea de Seguridad Alimentaria (EFSA), en la Unión Europea se notificaron más de 5.000 alertas, el 8% de las cuales tuvieron su origen en España.
Generalmente, este tipo de contaminaciones no son detectables a partir de las propiedades organolépticas de los alimentos, tales como su aspecto, olor o sabor. Para detectarlo, la industria alimentaria debe realizar, entre otros, distintos controles microbiológicos en laboratorios acreditados.
En AINIA estamos investigando la aplicación de tecnologías fotónicas e inteligencia artificial al control microbiológico de alimentos. Concretamente, hemos desarrollado un prototipo que facilita a los técnicos de los laboratorios la tarea del recuento de los microorganismos en las placas de cultivo de los análisis.
Con el proyecto DIGILAB se ha adaptado este conocimiento a las necesidades particulares de los laboratorios de análisis microbiológico. Para llevarlo a cabo, hemos creado un equipo de trabajo multidisciplinar, formado por ingenieros (en telecomunicación, electrónica y automática industrial) y por técnicos y especialistas en análisis microbiológico. Asimismo, hemos establecido una colaboración con investigadores en bioingeniería de la Universidad Politécnica de Valencia.
Hemos construido un prototipo de realidad aumentada para avanzar en la automatización de la tarea de recuento de colonias en las placas de cultivo. El prototipo está basado en tecnologías de visión avanzada por computador. Concretamente, cuenta con un sistema de iluminación LED flexible y con una cámara de alta resolución. De este modo, permite al usuario visualizar las placas de cultivos en una pantalla. Además, el prototipo ofrece otras funciones adicionales, tales como el ajuste de la imagen, la realización y registro del recuento en formato digital y la introducción de información para su posterior vinculación con LIMS (Laboratory Information Management System).
El prototipo ha sido evaluado por analistas cualificados del Laboratorio de Microbiología de AINIA. El laboratorio cuenta con diversas técnicas para el control de patógenos alimentarios, tales como Listeria monocytogenes, E.coli (STEC), Salmonella spp, norovirus o virus de la hepatitis A. No obstante, para la evaluación del prototipo se ha seleccionado un indicador microbiológico de la calidad higiénica de un alimento: el recuento de aerobios mesófilos.
Con DIGILAB, hemos conseguido automatizar la medida de este indicador logrando una reducción de los costes asociados y la obtención de resultados en un menor tiempo.
Actualmente, se están desarrollando los algoritmos de análisis de la colección de imágenes de cultivos microbiológicos generada. Para ello, se están evaluando técnicas de inteligencia artificial, una disciplina que incluye conceptos diversos como búsqueda, planificación, razonamiento, aprendizaje, percepción, visión, etc. En particular, de forma colaborativa con la Universidad Politécnica de Valencia seguimos trabajando con herramientas de aprendizaje automático, las cuales permiten realizar los recuentos de las colonias de manera automática.
La integración de Realidad Aumentada e Inteligencia Artificial permite a las empresas de alimentación realizar controles más exhaustivos y automatizados, reduciendo costes y riesgos.
Disponer de resultados más seguros sobre la inocuidad de sus productos y reducir así los costes derivados de los análisis, les ayuda a mejorar su competitividad y reducir las posibilidades de sufrir una crisis alimentaria.
El proyecto DIGILAB está financiado por el IVACE (Instituto Valenciano de Competitividad Empresarial) en el marco del convenio de colaboración con AINIA para desarrollar actividades de I+D+i que sea transferible al tejido industrial.


| Responsable | AINIA |
| Domicilio | Calle Benjamín Franklin, 5 a 11, CP 46980 Paterna (Valencia) |
| Finalidad | Atender, registrar y contactarle para resolver la solicitud que nos realice mediante este formulario de contacto |
| Legitimación | Sus datos serán tratados solo con su consentimiento, al marcar la casilla mostrada en este formulario |
| Destinatarios | Sus datos no serán cedidos a terceros |
| Derechos | Tiene derecho a solicitarnos acceder a sus datos, corregirlos o eliminarlos, también puede solicitarnos limitar su tratamiento, oponerse a ello y a la portabilidad de sus datos, dirigiéndose a nuestra dirección postal o a privacy@ainia.es |
| Más info | Dispone de más información en nuestra Política de Privacidad |
| DPD | Si tiene dudas sobre como trataremos sus datos o quiere trasladar alguna sugerencia o queja, contacte al Delegado de protección de datos en info@businessadapter.es o en el Formulario de atención al interesado |
Consiento el uso de mis datos personales para que atiendan mi solicitud, según lo establecido en su Política de Privacidad
Consiento el uso de mis datos para recibir información y comunicaciones comerciales de su entidad.
